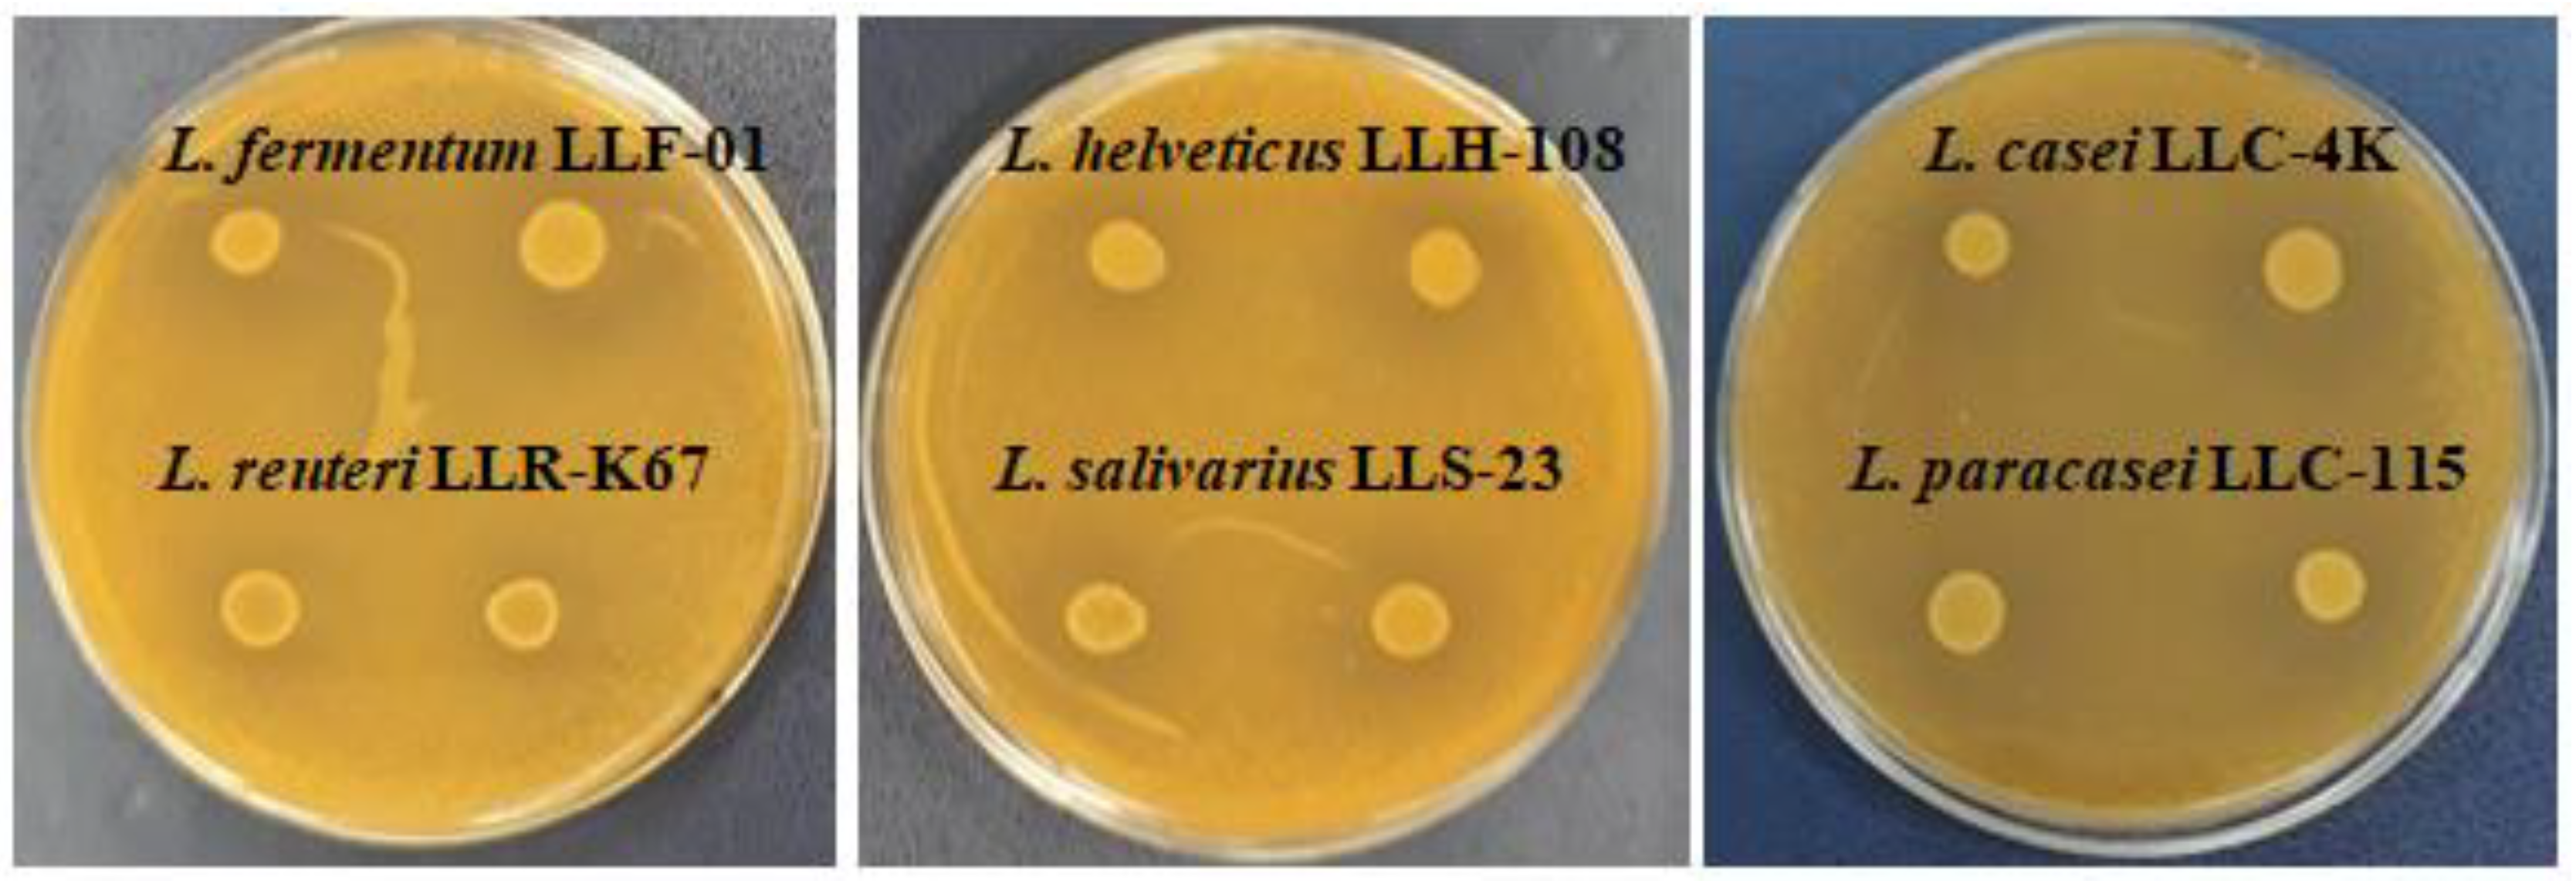
Microbiolres 15 00104 g001

In Vitro Inhibitory Effects and Co-Aggregation Activity of Lactobacilli on Candida albicans
Abstract
1. Introduction
2. Materials and Methods
2.1. Lactobacilli Strains
2.2. Test Organism
2.3. Agar Diffusion Assay
2.4. Agar Spot Assay
2.5. Growth Inhibition of C. albicans Using Co-Culture Assay
2.6. Co-Aggregation Assay
2.7. Statistical Analysis
3. Results
3.1. Agar Diffusion Assay and Agar Spot Assay
3.2. Growth Inhibition of C. albicans Using Co-Culture Assay
3.3. Co-Aggregation Assay
4. Discussion
5. Conclusions
Author Contributions
Funding
Institutional Review Board Statement
Informed Consent Statement
Data Availability Statement
Conflicts of Interest
References
- Gismondo, M.R.; Drago, L.; Lombardi, A. Review of probiotics available to modify gastrointestinal flora. Int. J. Antimicrob. Agents 1999, 12, 287–292. [Google Scholar] [CrossRef] [PubMed]
- Goldenberg, J.Z.; Lytvyn, L.; Steurich, J.; Parkin, P.; Mahant, S.; Johnston, B.C. Probiotics for the prevention of pediatric antibiotic-associated diarrhea. Cochrane Database Syst. Rev. 2015, 2015, CD004827. [Google Scholar] [CrossRef] [PubMed]
- Williams, D.W.; Jordan, R.P.C.; Wei, X.Q.; Alves, C.T.; Wise, M.P.; Wilson, M.J.; Lewis, M.A.O. Interactions of Candida albicans with host epithelial surfaces. J. Oral Microbiol. 2013, 5, 22434. [Google Scholar] [CrossRef] [PubMed]
- Mayer, F.L.; Wilson, D.; Hube, B. Candida albicans pathogenicity mechanisms. Virulence 2013, 4, 119–128. [Google Scholar] [CrossRef] [PubMed]
- Nucci, M.; Anaissie, E. Revisiting the source of candidemia: Skin or gut? Clin. Infect. Dis. 2001, 33, 1959–1967. [Google Scholar] [CrossRef] [PubMed]
- Matsubara, V.H.; Bandara, H.M.; Mayer, M.P.A.; Samaranayake, L.P. Probiotics as antifungals in mucosal candidiasis. Clin. Infect. Dis. 2016, 62, 1143–1153. [Google Scholar] [CrossRef]
- Sánchez-Vargas, L.O.; Ortiz-López, N.G.; Villar, M.; Moragues, M.D.; Aguirre, J.M.; Cashat-Cruz, M.; Lopez-Ribot, J.L.; Gaitán-Cepeda, J.A.; Quindós, G. Point prevalence, microbiology and antifungal susceptibility patterns of oral Candida isolates colonizing or infecting Mexican HIV/AIDS patients and healthy persons. Rev. Iberoam Micol. 2005, 22, 83–92. [Google Scholar] [CrossRef] [PubMed]
- Förster, T.M.; Mogavero, S.; Dräger, A.; Graf, K.; Polke, M.; Jacobsen, I.D.; Hube, B. Enemies and brothers in arms: Candida albicans and gram-positive bacteria. Cell. Microbiol. 2016, 18, 1709–1715. [Google Scholar] [CrossRef]
- Matsubara, V.H.; Wang, Y.; Bandara, H.M.; Mayer, M.P.A.; Samaranayake, L.P. Probiotic lactobacilli inhibit early stages of Candida albicans biofilm development by reducing their growth, cell adhesion, and filamentation. Appl. Microbiol. Biotechnol. 2016, 100, 6415–6426. [Google Scholar] [CrossRef]
- Falagas, M.E.; Betsi, G.I.; Athanasiou, S. Probiotics for prevention of recurrent vulvovaginal candidiasis: A review. J. Antimicrob. Chemother. 2006, 58, 266–272. [Google Scholar] [CrossRef]
- Kumar, S.; Singhi, S. Role of probiotics in prevention of Candida infection in critically ill children. Mycoses 2013, 56, 204–211. [Google Scholar] [CrossRef]
- Oncel, M.Y.; Arayici, S.; Sari, F.N.; Simsek, G.; Yurttutan, S.; Erdeve, O.; Saygan, S.; Uras, N.; Oguz, S.; Dilmen, U. Comparison of Lactobacillus reuteri and nystatin prophylaxis on Candida colonization and infection in very low birth weight infants. J. Matern.-Fetal Neonatal Med. 2015, 28, 1790–1794. [Google Scholar] [CrossRef]
- Osset, J.; García, E.; Bartolomé, R.M.; Andreu, A. Role of Lactobacillus as protector against vaginal candidiasis. Med. Clin. 2001, 117, 285–288. [Google Scholar] [CrossRef] [PubMed]
- Pepoyan, A.; Balayan, M.; Manvelyan, A.; Galstyan, L.; Pepoyan, S.; Petrosyan, S.; Tsaturyan, V.; Kamiya, S.; Torok, T.; Chikindas, M. Probiotic Lactobacillus acidophilus strain INMIA 9602 Er 317/402 administration reduces the numbers of Candida albicans and abundance of Enterobacteria in the gut microbiota of familial Mediterranean fever patients. Front. Immunol. 2018, 9, 1426. [Google Scholar] [CrossRef]
- Rossoni, R.D.; de Barros, P.P.; de Alvarenga, J.A.; Ribeiro, F.C.; Velloso, M.S.; Fuchs, B.B.; Mylonakis, E.; Jorge, A.O.C.; Junqueira, J.C. Antifungal activity of clinical Lactobacillus strains against Candida albicans biofilms: Identification of potential probiotic candidates to prevent oral candidiasis. Biofouling 2018, 34, 212–225. [Google Scholar] [CrossRef]
- Georgieva, R.; Yocheva, L.; Tserovska, L.; Zhelezova, G.; Stefanova, N.; Atanasova, A.; Danguleva, A.; Ivanova, G.; Karapetkov, N.; Rumyan, N.; et al. Antimicrobial activity and antibiotic susceptibility of Lactobacillus and Bifidobacterium spp. intended for use as starter and probiotic cultures. Biotechnol. Biotechnol. Equip. 2015, 29, 84–91. [Google Scholar] [CrossRef]
- Velikova, T.; Nakov, V.; Georgieva, R.; Toumangelova-Yuzeir, K.; Ivanova-Todorova, E.; Nakov, R.; Karaivanova, E.; Vladimirov, B.; Kyurkchiev, D. Immunomodulating properties of a novel synbiotic on healthy persons. Comptes Rendus Acad. Bulg. Sci. 2015, 68, 1321–1326. [Google Scholar]
- Velikova, T.; Tumangelova-Yuzeir, K.; Georgieva, R.; Ivanova-Todorova, E.; Karaivanova, E.; Nakov, V.; Nakov, R.; Kyurkchiev, D. Lactobacilli supplemented with larch arabinogalactan and colostrum stimulates an immune response towards peripheral NK activation and gut tolerance. Nutrients 2020, 12, 1706. [Google Scholar] [CrossRef]
- Schillinger, U.; Lücke, F.K. Antibacterial activity of Lactobacillus sake isolated from meat. Appl. Environ. Microbiol. 1989, 55, 1901–1906. [Google Scholar] [CrossRef]
- Campana, R.; Hemert, S.; Baffone, W. Strain-specific probiotic properties of lactic acid bacteria and their interference with human intestinal pathogens invasion. Gut Pathog. 2017, 9, 12. [Google Scholar] [CrossRef]
- Younes, J.A.; van der Mei, H.C.; van den Heuvel, E.; Busscher, H.J.; Reid, G. Adhesion forces and coaggregation between vaginal staphylococci and lactobacilli. PLoS ONE 2012, 7, e36917. [Google Scholar] [CrossRef]
- Mira, N.P.; Teixeira, M.C.; Sa-Correia, I. Adaptive response and tolerance to weak acids in Saccharomyces cerevisiae: A genome-wide view. OMICS 2010, 14, 525–540. [Google Scholar] [CrossRef] [PubMed]
- Strus, M.; Kucharska, A.; Kukla, G.; Brzychczy-Włoch, M.; Maresz, K.; Heczko, P.B. The in vitro activity of vaginal Lactobacillus with probiotic properties against Candida. Infect. Dis. Obstet. Gynecol. 2005, 13, 69–75. [Google Scholar] [CrossRef]
- Assefa, S.; Ahles, K.; Bigelow, S.; Curtis, J.T.; Köhler, G.A. Lactobacilli with probiotic potential in the prairie vole (Microtus ochrogaster). Gut Pathog. 2015, 7, 35. [Google Scholar] [CrossRef] [PubMed]
- Cleusix, V.; Lacroix, C.; Vollenweider, S.; Duboux, M.; Le Blay, G. Inhibitory activity spectrum of reuterin produced by Lactobacillus reuteri against intestinal bacteria. BMC Microbiol. 2007, 7, 101. [Google Scholar] [CrossRef] [PubMed]
- Ström, K.; Sjögren, J.; Broberg, A.; Schnürer, J. Lactobacillus plantarum MiLAB 393 produces the antifungal cyclic dipeptides cyclo(L-Phe-L-Pro) and cyclo(L-Phe-trans-4-OH-L-Pro) and 3-phenyllactic acid. Appl. Environ. Microbiol. 2002, 68, 4322–4327. [Google Scholar] [CrossRef] [PubMed]
- Wang, H.; Yan, Y.; Wang, J.; Zhang, H.P.; Qi, W. Production and characterization of antifungal compounds produced by Lactobacillus plantarum IMAU10014. PLoS ONE 2012, 7, e29452. [Google Scholar] [CrossRef]
- Gomaa, E.Z. Antimicrobial and anti-adhesive properties of biosurfactant produced by lactobacilli isolates, biofilm formation and aggregation ability. J. Gen. Appl. Microbiol. 2013, 59, 425–436. [Google Scholar] [CrossRef] [PubMed]
- De Gregorio, P.R.; Silva, J.A.; Marchesi, A.; Nader-Macías, M.E.F. Anti-Candida activity of beneficial vaginal lactobacilli in in vitro assays and in a murine experimental model. FEMS Yeast Res. 2019, 19, foz008. [Google Scholar] [CrossRef]
- Chew, S.Y.; Cheah, Y.K.; Seow, H.F.; Sandai, P.D.; Than, L.T.L. Probiotic Lactobacillus rhamnosus GR-1 and Lactobacillus reuteri RC-14 exhibit strong antifungal effects against vulvovaginal candidiasis-causing Candida glabrata isolates. J. Appl. Microbiol. 2015, 118, 1180–1190. [Google Scholar] [CrossRef]
- Köhler, G.A.; Assefa, S.; Reid, G. Probiotic interference of Lactobacillus rhamnosus GR-1 and Lactobacillus reuteri RC-14 with the opportunistic fungal pathogen Candida albicans. Infect. Dis. Obstet. Gynecol. 2012, 2012, 636474. [Google Scholar]
- Papadimitriou, K.; Zoumpopoulou, G.; Foligné, B.; Alexandraki, V.; Kazou, M.; Pot, B.; Tsakalidou, E. Discovering probiotic microorganisms: In vitro, in vivo, genetic and omics approaches. Front. Microbiol. 2015, 6, 58. [Google Scholar] [CrossRef] [PubMed]
- Zheng, J.; Wittouck, S.; Salvetti, E.; Franz, C.M.A.P.; Harris, H.M.B.; Mattarelli, P.; O’Toole, P.W.; Pot, B.; Vandamme, P.; Walter, J.; et al. A taxonomic note on the genus Lactobacillus: Description of 23 novel genera, emended description of the genus Lactobacillus Beijerinck 1901, and union of Lactobacillaceae and Leuconostocaceae. Int. J. Syst. Evol. Microbiol. 2020, 70, 2782–2858. [Google Scholar] [CrossRef] [PubMed]
- Carmo, M.S.; Noronha, F.M.F.; Arruda, M.O.; Costa, E.P.d.S.; Bomfim, M.R.Q.; Monteiro, A.S.; Ferro, T.A.F.; Fernandes, E.S.; Girón, J.A.; Monteiro-Neto, V. Lactobacillus fermentum ATCC 23271 displays in vitro inhibitory activities against Candida spp. Front. Microbiol. 2016, 7, 1722. [Google Scholar] [CrossRef]
- Orsi, C.F.; Sabia, C.; Ardizzoni, A.; Colombari, B.; Neglia, R.G.; Peppoloni, S.; Morace, G.; Blasi, E. Inhibitory effects of different lactobacilli on Candida albicans hyphal formation and biofilm development. J. Biol. Regul. Homeost. Agents 2014, 28, 743–752. [Google Scholar]
- Xu, Z.; Li, Y.; Xu, A.; Xue, L.; Soteyome, T.; Yuan, L.; Ma, Q.; Seneviratne, G.; Hong, W.; Mao, Y.; et al. Differential alteration in Lactiplantibacillus plantarum subsp. plantarum quorum-sensing systems and reduced Candida albicans yeast survival and virulence gene expression in dual-species interaction. Microbiol. Spectr. 2024, 12, e0035324. [Google Scholar] [CrossRef]
- Yang, E.; Fan, L.; Yan, J.; Jiang, Y.; Doucette, C.; Fillmore, S.; Walker, B. Influence of culture media, pH and temperature on growth and bacteriocin production of bacteriocinogenic lactic acid bacteria. AMB Expr. 2018, 8, 10. [Google Scholar] [CrossRef] [PubMed]
- Reid, G.; McGroarty, J.A.; Angotti, R.; Cook, R.L. Lactobacillus inhibitor production against Escherichia coli and coaggregation ability with uropathogens. Can. J. Microbiol. 1988, 34, 344–351. [Google Scholar] [CrossRef]
- Jørgensen, M.R.; Kragelund, C.; Jensen, P.Ø.; Keller, M.K.; Twetman, S. Probiotic Lactobacillus reuteri has antifungal effects on oral Candida species in vitro. J. Oral Microbiol. 2017, 9, 1274582. [Google Scholar] [CrossRef]
- Gil, N.F.; Martinez, R.C.R.; Gomes, B.C.; Nomizo, A.; de Martinis, E.C.P. Vaginal lactobacilli as potential probiotics against Candida spp. Braz. J. Microbiol. 2010, 41, 6–14. [Google Scholar] [CrossRef]
- Boris, S.; Suárez, J.E.; Vázquez, F.; Barbés, C. Adherence of human vaginal lactobacilli to vaginal epithelial cells and interaction with uropathogens. Infect. Immun. 1998, 66, 1985–1989. [Google Scholar] [CrossRef] [PubMed]
- Salari, S.; Almani, P.G.N. Antifungal effects of Lactobacillus acidophilus and Lactobacillus plantarum against different oral Candida species isolated from HIV/AIDS patients: An in vitro study. J. Oral Microbiol. 2020, 12, 1769386. [Google Scholar] [CrossRef] [PubMed]
- Verdenelli, M.C.; Coman, M.M.; Cecchini, C.; Silvi, S.; Orpianesi, C.; Cresci, A. Evaluation of antipathogenic activity and adherence properties of human Lactobacillus strains for vaginal formulations. J. Appl. Microbiol. 2014, 116, 297–307. [Google Scholar] [CrossRef] [PubMed]

| Sources of Isolation | Species/Strain | |
|---|---|---|
| Dairy | Home-made yogurt | Lactobacillus delbrueckii subsp. bulgaricus LLB-02 |
| L. delbrueckii subsp. bulgaricus LLB-05 | ||
| L. delbrueckii subsp. bulgaricus LLB-06 | ||
| Lactiplantibacillus plantarum LLP-4B | ||
| Yellow cheese whey | Lactobacillus delbrueckii subsp. lactis LLL-14 | |
| Cheese | Lacticaseibacillus rhamnosus LLR-L2 | |
| Lacticaseibacillus casei LLC-4K | ||
| Human origin | Infant feces | Lactobacillus acidophilus LLA-01 |
| L. delbrueckii subsp. lactis LLL-F18 | ||
| Lactobacillus helveticus LLH-108 | ||
| Lacticaseibacillus paracasei LLC-J31 | ||
| L. paracasei LLC-J35 | ||
| L. paracasei LLC-115 | ||
| L. rhamnosus LLR-L1 | ||
| Limosilactobacilllus reuteri LLR-K67 | ||
| Vagina | L. reuteri LLR-V31 | |
| Lactobacillus gasseri LLG-V33 | ||
| L. gasseri LLG-V74 | ||
| L. rhamnosus LLR-V57 | ||
| Saliva | Limosilactobacilllus fermentum LLF-01 | |
| Ligilactobacillus salivarius LLS-23 | ||
| Others | Raw-dried sausages | L. plantarum LLP-2L |
| Plant | L. delbrueckii subsp. bulgaricus LKZ-200 | |
| Geranium sanguineum | ||
| Strains | Inhibition Zone (mm) ADA/ASA | Strains | Inhibition Zone (mm) ADA/ASA |
|---|---|---|---|
| L. bulgaricus LLB-02 | 0/0 | L. rhamnosus LLR-L2 | 0/8.0 (±0) |
| L. bulgaricus LLB-05 | 0/0 | L. rhamnosus LLR-V57 | 0/8.0 (±2.3) |
| L. bulgaricus LLB-06 | 0/0 | L. casei LLC-4K | 11.0(±1.0)/7.0 (±1.2) |
| L. bulgaricus LKZ-200 | 0/0 | L. paracasei LLC-J31 | 0/6.0 (±0) |
| L. lactis LLL-14 | 0/0 | L. paracasei LLC-J35 | 0/6.5 (±1.0) |
| L. lactis LLL-F18 | 0/0 | L. paracasei LLC-115 | 0/9.5 (±1.9) |
| L. helveticus LLH-108 | 0/7.5 (±1.9) | L. plantarum LLP-4B | 14.0 (±1.0)/9.0 (±1.2) |
| L. acidophilus LLA-01 | 0/0 | L. plantarum LLP-2L | 0/8.0 (±1.6) |
| L. gasseri LLG-V33 | 0/0 | L. fermentum LLF-01 | 12.6 (±1.2)/10.5 (±1.7) |
| L. gasseri LLG-V74 | 0/0 | L. reuteri LLR-K67 | 0/6.0 (±0) |
| L. salivarius LLS-23 | 0/7.0 (±1.2) | L. reuteri LLR-V31 | 0/0 |
| L. rhamnosus LLR-L1 | 14.3 (±1.2)/7.5 (±1.9) |
| Lactobacilli Strains | Growth Reduction (%) of C. albicans | |||
|---|---|---|---|---|
| MRS Broth Model System | BHI Broth Model System | |||
| C. albcans + Cells | C. albicans + Supernatants | C. albicans + Cells | C. albicans + Supernatants | |
| L. bulgaricus LLB-02 | 21.2 (±4.9) Aac | 9.7 (±3.6) Ba | 11.4 (±2.7) Aac | 5.9 (±2.0) Ba |
| L. bulgaricus LLB-05 | 12.1 (±5.4) Ac | 4.7 (±1.2) Ba | 2.0 (±1.7) Abcd | 5.4 (±0.5) Ba |
| L. bulgaricus LLB-06 | 14.0 (±0.7) Aac | 5.1 (±1.0) Ba | 12.2 (±4.2) Aac | 6.2 (±2.7) Ba |
| L. bulgaricus LKZ-200 | 14.4 (±5.1) Aac | 3.9 (±1.4) Ba | 9.5 (±2.9) Aac | 4.3 (±1.0) Ba |
| L. lactis LLL-14 | 20.7 (±2.4) Aac | 5.4 (±1.3) Ba | 5.5 (±4.0) Abcd | 2.7 (±1.4) Aa |
| L. lactis LLL-F18 | 24.6 (±3.5) Aa | 6.6 (±1.2) Ba | 9.6 (±2.2) Aac | 2.8 (±0.9) Ba |
| L. helveticus LLH-108 | 22.5 (±3.9) Aac | 9.2 (±2.7) Ba | 4.2 (±2.2) Abcd | 2.2 (±0.8) Aa |
| L. acidophilus LLA-01 | 6.5 (±1.1) Abc | 3.5 (±0.8) Ba | 7.8 (±2.7) Aacd | 4.5 (±1.2) Ba |
| L. gasseri LLG-V33 | 5.7 (±1.3) Ab | 3.9 (±0.8) Ba | 6.5 (±1.6) Aabcd | 3.3 (±2.5) Ba |
| L. gasseri LLG-V74 | 6.4 (±1.8) Abc | 7.5 (±1.5) Ba | 6.5 (±2.1) Aabcd | 3.8 (±1.0) Ba |
| L. salivarius LLS-23 | 18.6 (±1.9) Aac | 4.8 (±1.4) Ba | 8.0 (±2.9) Aacd | 6.4 (±3.3) Aa |
| L. rhamnosus LLR-L1 | 28.2 (±3.2) Aa | 7.3 (±4.2) Ba | 7.1 (±2.7) Aabcd | 6.5 (±3.6) Aa |
| L. rhamnosus LLR-L2 | 26.6 (±3.6) Aa | 8.6 (±5.1) Ba | 7.2 (±3.2) Aabcd | 5.1 (±2.3) Aa |
| L. rhamnosus LLR-V57 | 24.7 (±4.6) Aac | 7.6 (±3.7) Ba | 9.9 (±2.9) Aac | 7.3 (±1.2) Aa |
| L. casei LLC-4K | 25.1 (±3.0) Aa | 5.0 (±2.9) Ba | 8.5 (±3.2) Aacd | 7.7 (±4.1) Aa |
| L. paracasei LLC-J31 | 23.1 (±2.2) Aac | 6.5 (±2.2) Ba | 10.3 (±2.9) Aac | 7.9 (±4.5) Aa |
| L. paracasei LLC-J35 | 20.3 (±1.6) Aac | 5.5 (±1.6) Ba | 11.8 (±4.9) Aacd | 6.9 (±1.6) Aa |
| L. paracasei LLC-115 | 25.0 (±3.3) Aa | 6.6 (±1.9) Ba | 17.1 (±2.2) Aa | 4.7 (±3.2) Ba |
| L. plantarum LLP-4B | 26.1 (±5.1) Aac | 5.4 (±0.7) Ba | 8.1 (±2.8) Aacd | 7.1 (±2.9) Aa |
| L. plantarum LLP-2L | 21.5 (±4.2) Aac | 6.3 (±2.3) Ba | 10.2 (±5.5) Aacd | 7.6 (±1.6) Aa |
| L. fermentum LLF-01 | 28.9 (±2.4) Aa | 5.1 (±3.1) Ba | 14.3 (±2.7) Aa | 4.0 (±3.3) Ba |
| L. reuteri LLR-K67 | 28.3 (±3.1) Aa | 6.9 (±0.6) Ba | 14.9 (±3.4) Aa | 7.9 (±2.9) Ba |
| L. reuteri LLR-V31 | 21.6 (±2.9) Aac | 5.2 (±1.2) Ba | 7.1 (±3.6) Aabcd | 5.9 (±1.3) Aa |
Disclaimer/Publisher’s Note: The statements, opinions and data contained in all publications are solely those of the individual author(s) and contributor(s) and not of MDPI and/or the editor(s). MDPI and/or the editor(s) disclaim responsibility for any injury to people or property resulting from any ideas, methods, instructions or products referred to in the content. |
© 2024 by the authors. Licensee MDPI, Basel, Switzerland. This article is an open access article distributed under the terms and conditions of the Creative Commons Attribution (CC BY) license (https://creativecommons.org/licenses/by/4.0/).
Share and Cite
Yocheva, L.; Tserovska, L.; Danguleva-Cholakova, A.; Todorova, T.; Zhelezova, G.; Karaivanova, E.; Georgieva, R. In Vitro Inhibitory Effects and Co-Aggregation Activity of Lactobacilli on Candida albicans. Microbiol. Res. 2024, 15, 1576-1589. https://doi.org/10.3390/microbiolres15030104
Yocheva L, Tserovska L, Danguleva-Cholakova A, Todorova T, Zhelezova G, Karaivanova E, Georgieva R. In Vitro Inhibitory Effects and Co-Aggregation Activity of Lactobacilli on Candida albicans. Microbiology Research. 2024; 15(3):1576-1589. https://doi.org/10.3390/microbiolres15030104
Chicago/Turabian StyleYocheva, Lyubomira, Lilia Tserovska, Antonia Danguleva-Cholakova, Teodora Todorova, Galina Zhelezova, Elena Karaivanova, and Ralitsa Georgieva. 2024. "In Vitro Inhibitory Effects and Co-Aggregation Activity of Lactobacilli on Candida albicans" Microbiology Research 15, no. 3: 1576-1589. https://doi.org/10.3390/microbiolres15030104
APA StyleYocheva, L., Tserovska, L., Danguleva-Cholakova, A., Todorova, T., Zhelezova, G., Karaivanova, E., & Georgieva, R. (2024). In Vitro Inhibitory Effects and Co-Aggregation Activity of Lactobacilli on Candida albicans. Microbiology Research, 15(3), 1576-1589. https://doi.org/10.3390/microbiolres15030104

